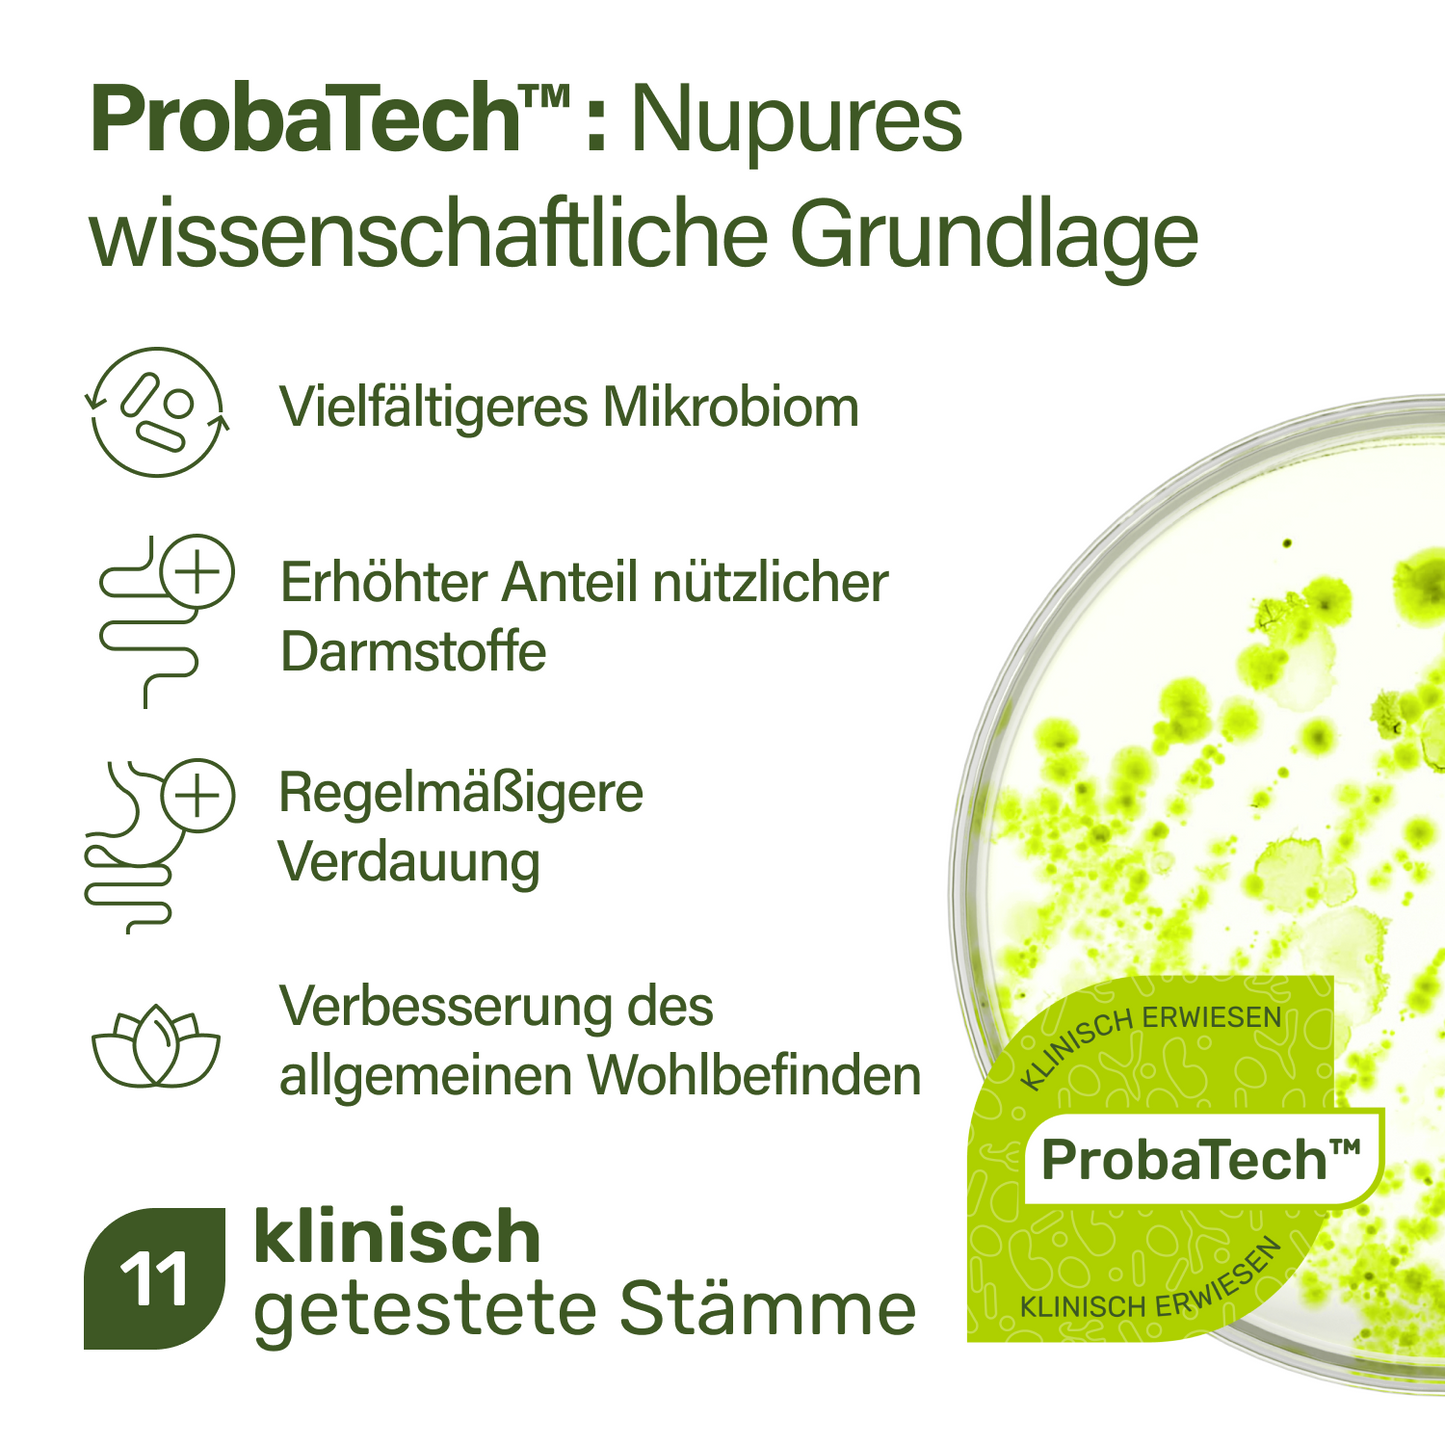
probaflor

probaflor
probaflor
Aktuell sehr beliebt!
- Preisgekrönte 2-in-1-Formel mit hoher KBE-Zahl
- Nach dem Vorbild Ihres natürlichen Darmmikrobioms
- Einzigartige Vielfalt: Ausgewählte Milchsäurebakterienstämme, die in einem breiten pH-Bereich gedeihen
- Enthält 30 mg Inulin
 Mrd. KBE pro Kapsel345 KBE Mrd. pro Gramm
Mrd. KBE pro Kapsel345 KBE Mrd. pro Gramm Milchsäurebakterienstämmesorgfältig ausgewählt, um den Darm zu besiedeln
Milchsäurebakterienstämmesorgfältig ausgewählt, um den Darm zu besiedeln ProbaTech™Nupures eigene klinisch geprüfte Stammformel
ProbaTech™Nupures eigene klinisch geprüfte Stammformel
Entdecken Sie Ihre Probaflor-Variante:
Mehr kaufen, mehr sparen!



Verfügbarkeit für Abholungen konnte nicht geladen werden

Bezahlen nach 30 Tagen mit Klarna.
-
Gratis Versand ab € 30
-
Lieferzeit 1-2 Werktage
-
90-Tage-Geld-zurück-Garantie
















probaflor
-
Ohne Zucker
-
Ohne Gluten
-
GVO-frei
-
Ohne Fruktose
-
100 % natürlich
-
Apotheken-Qualität
Einklappbarer Inhalt
Inhaltsstoffe
Füllstoff: natürliche Maisstärke; Probaflor Mix [Bifidobacterium animalis ssp. lactis BLC 1, Lactobacillus plantarum 14D, Lactobacillus delbrueckii ssp. lactis LL 82, Lactobacillus acidophilus LA1, Streptococcus thermophilus Z57, Bifidobacterium bifidum SP 9, Bifidobacterium longum ssp. longum SP 54, Lactobacillus rhamnosus SP 1, Lactobacillus casei BGP 93, Lactobacilus delbrueckii ssp. bulgaricus LB2, Lactobacillus salivarius SP 2], Hydroxypropylmethylcellulose, Pektin (Kapselhülle), Chicoréewurzelpulver mit 88% Inulin, Trennmittel: Magnesiumsalze der Speisefettsäuren
Einnahmehinweise
Erwachsene nehmen täglich eine Kapsel unzerkaut mit ausreichend Flüssigkeit ein. Probaflor sollte etwa 10-20 Minuten vor dem Essen eingenommen werden. Diese Kapseln sind ausschließlich für die Darmflora von Erwachsenen geeignet.
Wichtige Hinweise
Nupure Probaflor wurde speziell für die Darmflora von Erwachsenen entwickelt und ist nicht für Kinder geeignet. Die angegebene empfohlene tägliche Verzehrmenge darf nicht überschritten werden. Nahrungsergänzungsmittel sind kein Ersatz für eine ausgewogene und abwechslungsreiche Ernährung und eine gesunde Lebensweise. In der Schwangerschaft und Stillzeit nicht einnehmen.
-
95 %des Glückshormons Serotonin wird im Darm produziert.
-
8wichtige Vitamine werden von Bakterien im Darm produziert
-
80 %der aktiven Immunzellen befinden sich im Darm
ProbaTech™ – klinisch geprüfte Grundlage

Proba Reise Magen Darm komplett enthält ProbaTech™, Nupures proprietäre Mischung aus 11 ausgewählten Milchsäurebakterienstämmen.
In einer 12-wöchigen, randomisierten, doppelblinden, placebo-kontrollierten Studie mit gesunden Erwachsenen zeigte ProbaTech™:
- Erhöhte mikrobielle Vielfalt im Darm
- Bis zu 35 % mehr nützliche, im Darm gebildete Stoffe (SCFAs)
- Unterstützung einer regelmäßigen Verdauung
- Verbesserte Werte im gastrointestinalen Wohlbefinden

Garantiert hohe Dosierung
Probaflor hat eine garantierte Dosierung von 20 Milliarden KBE bis zum Ende der Haltbarkeit. Um eine hohe Überlebensrate der Bakterien zu gewährleisten, verwenden wir spezielle Activ-Vial™-Dosen, die mit einem aktiven Polymer beschichtet sind, das Feuchtigkeit effektiv absorbiert und die Bakterien stabil hält.

Strenge Stabilitäts- und Reinheitsprüfungen
Probaflor enthält 11 Bakterienstämme und 20 Milliarden KBE pro Kapsel. Jede Charge von Probaflor wird nach den höchsten EU-Standards hergestellt und strengen Tests unterzogen, um sowohl die Reinheit als auch die hohe Dosierung zu gewährleisten. Um die Integrität der Bakterien zu erhalten und die Haltbarkeit zu verlängern, wird die Probaflor-Rezeptur schonend gefriergetrocknet. Dieses sorgfältige Verfahren gewährleistet eine langfristige Stabilität und unterstützt die effiziente Abgabe und Qualität.

Inulin: Die Lieblingsspeise der Darmbakterien
Inulin wird aus Chicorée gewonnen und ist völlig natürlich. Es wirkt wie ein Ballaststoff und wird vom Körper nicht verstoffwechselt. Gelangt es unverdaut in den Darm, kann es den Bakterien als Nahrung dienen.
Fachliche Einblicke mit Dr. Simon Hörster

"Ein gesundes Mikrobiom ist kein Zufallsprodukt, sondern das Resultat bewusster Entscheidungen – Tag für Tag. Ein fundiertes Verständnis, gesunde Routinen und passende Unterstützung mit vielfältigen lebenden Bakterienstämmen können die Darmgesundheit gezielt fördern – und damit das gesamte Wohlbefinden."
Dr. Simon Hörster
Internist, Gastroenterologe & Ernährungsmediziner
Sorgfältig ausgewählte Zutaten












Wo ist probaflor erhältlich?
Im stressigen Alltag und schnellem Essen habe ich etwas gesucht, um meinen Darm zu entlasten und zu unterstützen.
Ich nehme probaflor Max Spektrum N95 nun seit etwa 2 Wochen und kann auf jeden Fall schon eine Verbesserung feststellen.
Ich fühle mich fitter und allgemein wohler.
Nach 3 Tagen Einnahme merke ich einen Rückgang der Heißhungerattacken.
Ich nehm sie jetzt seit ca 1 Woche und es geht mir soooooo gut. Ich hab keinen aufgeblähten Bauch mehr fühl mich auch sonst nicht mehr so träge.
Ich hab es schon weiterempfohlen und werde mir noch mind 1. Packung holen.
Sehr gutes Produkt, ich bin überzeugt 👍🏻
Ich habe das probaflor MAX SPEKTRUM N95 ausprobiert und bin wirklich zufrieden. Es hält, was es verspricht, und ich vertrage es ausgezeichnet.
Die Qualität wirkt sehr hochwertig und die Lieferung war auch fix. Seit ich es nehme, habe ich ein gutes Gefühl im Bauch.
Daumen hoch, würde ich definitiv wieder kaufen!
FAQ
-
Was ist nupure probaflor?
Nupure probaflor ist ein Präparat mit Bakterienkulturen. Diese gehören zu den natürlichen Besiedlern des Darms, wo sie verschiedene wichtige Aufgaben erfüllen.
-
Wie lange sollte ich nupure probaflor einnehmen?
Nupure probaflor kann problemlos dauerhaft angewendet werden. Wir empfehlen eine mindestens 4–12-wöchige Einnahme, um den Bakterien ausreichend Zeit zu geben sich anzusiedeln.
-
Warum enthält nupure probaflor Inulin?
Inulin ist ein Ballaststoff, der vom Menschen nicht verdaut werden kann. Der dient den wichtigen Darmbakterien im Darm als Nährstoff.
-
Ist das Produkt für Kinder geeignet?
Nein. Nupure probaflor ist ab 18 Jahren geeignet. Für Kinder ab drei Jahren haben wir ein speziell entwickeltes Produkt im Sortiment.
-
Muss das Produkt im Kühlschrank aufbewahrt werden?
Nupure probaflor muss nicht im Kühlschrank aufbewahrt werden. Bei sehr hohen Außentemperaturen können Sie nupure probaflor jedoch im Kühlschrank lagern. Achten Sie darauf, dass die Dose fest verschlossen ist, damit keine Feuchtigkeit eindringen kann.
-
Enthält das Produkt Laktose?
Nein, das Produkt enthält keine Laktose.
-
Ist das Produkt gentechnikfrei?
Ja, nupure probaflor ist GMO- frei, also frei von gentechnisch veränderten Organismen.
-
Sind die Kapseln magensaftresistent?
Ja, die Kapselhülle ist magensaftresistent.

Wie können wir Ihnen helfen?
-
 E-Mail an info@nupureshop.com
E-Mail an info@nupureshop.com -
 Anruf unter +49 (0)8276 5187790
Anruf unter +49 (0)8276 5187790 -
WhatsApp: +49 (0)8276 9099967
Bleiben Sie auf dem Laufenden
Exklusive Sonderangebote, Produkteinführungen sowie die neuesten wissenschaftlichen Erkenntnisse stets in Ihrem Posteingang.